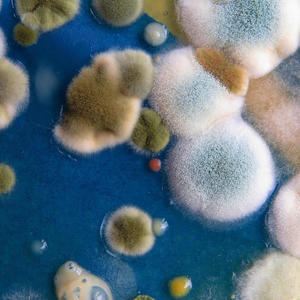

Mecca Tha Marvelous
最新歌曲
-
Mecca Tha Marvelous、Redd Smoke 2.14 MB 02:20
-
Mecca Tha Marvelous 1.54 MB 01:41
-
RatedDont3、Mecca Tha Marvelous 3.26 MB 03:33
-
Mecca Tha Marvelous 2.3 MB 02:30
-
Mecca Tha Marvelous、FÈLA ALOCHI 2.04 MB 02:13
-
Mecca Tha Marvelous 3.53 MB 03:51
-
Mecca Tha Marvelous、Freddy Bricks 3.63 MB 03:57
-
Mecca Tha Marvelous 1.99 MB 02:10
-
Mecca Tha Marvelous 1.02 MB 01:06
-
Darren Robert、Mecca Tha Marvelous 2.38 MB 02:35
-
Jeremy Ryan、Redd Smoke、Mecca Tha Marvelous、FredoThaGawd、Dree The Astrologist 3.27 MB 03:33
-
Jeremy Ryan、Redd Smoke、Mecca Tha Marvelous 4.01 MB 04:22
-
Jeremy Ryan、Redd Smoke、Mecca Tha Marvelous 2.06 MB 02:14
-
Jeremy Ryan、Redd Smoke、Mecca Tha Marvelous 3.22 MB 03:30
-
Jeremy Ryan、Redd Smoke、Mecca Tha Marvelous 2.35 MB 02:33
-
Jeremy Ryan、Redd Smoke、Mecca Tha Marvelous、yannaSOUL 2.27 MB 02:28
-
Jeremy Ryan、Redd Smoke、Mecca Tha Marvelous 3.23 MB 03:31
-
EASYin2D、Mecca Tha Marvelous 2.33 MB 02:32
-
EASYin2D、Mecca Tha Marvelous、FredoThaGawd 2.82 MB 03:05
-
Freddy Bricks、Mecca Tha Marvelous 2.33 MB 02:32
-
Mecca Tha Marvelous 2.44 MB 02:40
-
Mecca Tha Marvelous 1.92 MB 02:05
-
Mecca Tha Marvelous 2.56 MB 02:47
-
Mecca Tha Marvelous 2.14 MB 02:20
-
Mecca Tha Marvelous、Matt Schultz 2.09 MB 02:17
-
Mecca Tha Marvelous、Freddy Bricks 2.75 MB 02:59
-
Mecca Tha Marvelous 2.24 MB 02:26
-
Mecca Tha Marvelous 1.21 MB 01:19
-
DevDiedAlone、Mecca Tha Marvelous 3.29 MB 03:35
-
FredoThaGawd、Mecca Tha Marvelous 2.72 MB 02:57
-
CAB 3、Mecca Tha Marvelous 3.78 MB 04:07
-
SOUFSIDE RICO、BROTHAVUDU、Mecca Tha Marvelous 2.42 MB 02:38
-
Mecca Tha Marvelous 1.7 MB 01:51
-
Mecca Tha Marvelous 2.11 MB 02:18
-
Mecca Tha Marvelous、Redd Smoke 2.44 MB 02:40
-
Mecca Tha Marvelous 2.18 MB 02:23
-
Mecca Tha Marvelous 2.68 MB 02:55
-
Jeremy Ryan、Mecca Tha Marvelous、eSQUIRE、yannaSOUL、Ebony Payne-English、K.UTIE 4.43 MB 04:50
-
Jeremy Ryan、Mecca Tha Marvelous、Jaiquan Tyre、Mizzy Raw 4.06 MB 04:25
-
Jeremy Ryan、Mecca Tha Marvelous、John Wes 3.99 MB 04:21
-
Jeremy Ryan、Mecca Tha Marvelous、Alan Prorock、IAmAura、K.delor 3.95 MB 04:18
-
Jeremy Ryan、Mecca Tha Marvelous 3.31 MB 03:36
-
Jeremy Ryan、Mecca Tha Marvelous、DevDiedAlone 3.1 MB 03:23
-
Jeremy Ryan、Mecca Tha Marvelous、Ebonique 2.84 MB 03:06
-
Jeremy Ryan、Mecca Tha Marvelous 2.87 MB 03:08
-
Jeremy Ryan、Mecca Tha Marvelous 2.81 MB 03:03
-
Jeremy Ryan、Mecca Tha Marvelous、Dree The Astrologist、Blu Flutur 2.31 MB 02:31
-
Jeremy Ryan、Mecca Tha Marvelous 2.06 MB 02:14
-
Mecca Tha Marvelous 1.81 MB 01:58
-
FredoThaGawd、Mecca Tha Marvelous 2.75 MB 03:00
-
Mecca Tha Marvelous、Alan Prorock 2.97 MB 03:14
-
Mecca Tha Marvelous、Qweenrah 2.31 MB 02:31
-
Mecca Tha Marvelous、Ktree 2.24 MB 02:26
-
Mecca Tha Marvelous 2.22 MB 02:25
-
Mecca Tha Marvelous 1.65 MB 01:48
-
Mecca Tha Marvelous 2.35 MB 02:33